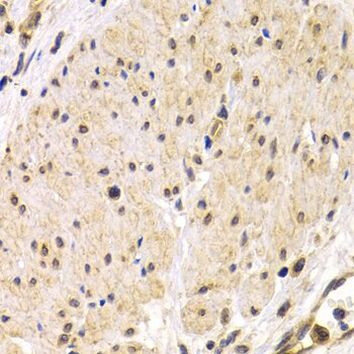
TMPRSS2 Antibody in Immunohistochemistry (IHC)

Search
Invitrogen
TMPRSS2 Polyclonal Antibody
{{$productOrderCtrl.translations['antibody.pdp.commerceCard.promotion.promotions']}}
{{$productOrderCtrl.translations['antibody.pdp.commerceCard.promotion.viewpromo']}}
{{$productOrderCtrl.translations['antibody.pdp.commerceCard.promotion.promocode']}}: {{promo.promoCode}} {{promo.promoTitle}} {{promo.promoDescription}}. {{$productOrderCtrl.translations['antibody.pdp.commerceCard.promotion.learnmore']}}


Please note: We are reviewing Western blot images included in the antibody testing data in our catalog, including those provided by third parties. Unless expressly labeled or annotated as “raw-unedited”, Western blot images included in the antibody testing data in our catalog may have been edited, optimized or otherwise adjusted for presentation.
产品信息
PA5-96019
宿主/亚型
分类
类型
抗原
偶联物
形式
浓度
规格
保存条件
运输条件
RRID
产品详细信息
Immunogen sequence: GLLWKFMGSK CSNSGIECDS SGTCINPSNW CDGVSHCPGG EDENRCVRLY GPNFILQVYS SQRKSWHPVC QDDWNENYGR AACRDMGYKN NFYSSQGIVD DSGSTSFMKL NTSAGNVDIY KKLYHSDACS SKAVVSLRCI ACGVNLNSSR QSRIVGGESA LPGAWPWQVS LHVQNVHVCG GSIITPEWIV TAAHCVEKPL NNPWHWTAFA GILRQSFMFY GAGYQVEKVI SHPNYDSKTK NNDIALMKLQ KPLTFNDLVK P; Positive Samples: 22Rv1; Cellular Location: Cell membrane, Single-pass type II membrane protein
靶标信息
TMPRSS2 is a protein that belongs to the serine protease family. The protein contains a type II transmembrane domain, a receptor class A domain, a scavenger receptor cysteine-rich domain and a protease domain. Serine proteases are known to be involved in many physiological and pathological processes. Its gene was demonstrated to be up-regulated by androgenic hormones in prostate cancer cells and down-regulated in androgen-independent prostate cancer tissue. The protease domain of this protein is thought to be cleaved and secreted into cell media after autocleavage.
仅用于科研。不用于诊断过程。未经明确授权不得转售。